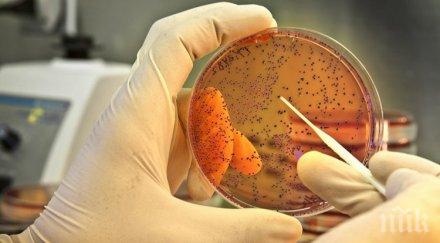
причина смъртта британските туристи египет ешерихия коли

ГОРЕЩО
Болезнени думи за краха на "Исторически парк": Ивелин Михайлов обещаваше на инвеститорите Дисниленд с мирис на босилек и история, а им даде бетонен макет с привкус на финансова пирамида
Стана ясно кога се е върнал във Варна Олег Невзоров - полицията го разпитва
ЗАРАДИ 81 МИЛИОНА ЛЕВА: Калин Стоянов даде Демерджиев на главния прокурор
Радев посрещна Кристалина Георгиева в Министерски съвет - сподели й какви са приоритетите на кабинета
ГОРЕЩО В ПИК: Делян Добрев официално поиска да бъде освободен като депутат

Митничари спипаха нелегален алкохол по обява в интернет
14039
на 19.12.2018

5 домашни цяра срещу артрит
33577
на 15.12.2018

ТАЙНИ КЛИЕНТИ: Митничари спипаха нелегален алкохол по обява в интернет
15995
на 07.12.2018

ПРЕДКОЛЕДЕН УДАР: Откриха един тон нелегален алкохол в къща край Пловдив
12934
на 14.11.2018

АКЦИЯ: Бургаски митничари удариха нелегалните казани за ракия
39417
на 09.11.2018

ОТ ПОСЛЕДНИТЕ МИНУТИ! Заработиха трите завода на Миню Стайков в Карнобат
33383
на 25.09.2018

РЕВОЛЮЦИЯ! В Русия вдигат алкохолната възраст от 18 на 21 г.
5558
на 24.09.2018
Причина за смъртта на британските туристи в Египет е ешерихия коли
21941
на 12.09.2018

Заловиха 1 тон нелегален алкохол във Варна (СНИМКИ)
10531
на 03.09.2018

Над 500 литра нелегален алкохол заловиха митничари в Бургас
11354
на 30.08.2018

УДАР! Кръчмите в Несебър на сухо - спипаха един тон нелегален алкохол
14668
на 10.08.2018

АКЦИЯ! Иззеха над 5 тона нелегален алкохол по Черноморието
11400
на 17.07.2018

Разбиха канал за трафик на етилов алкохол към ЕС
11152
на 12.06.2018

СКАНДАЛ! Поредната измама: менте на оцет от петролни деривати
542740
на 31.05.2018

Спипаха 18 хиляди литра нелегален спирт на ГКПП Кулата (СНИМКИ)
12604
на 28.05.2018

Задържаха 340 литра нелегален етилов алкохол на магистрала "Тракия"
31834
на 16.05.2018
ПОСЛЕДНИ НОВИНИ

Двама чужденци дадоха фира на Слънчака
167
преди 1 минута

Министър Иван Шишков представя екипа си в МРРБ
1319
преди 6 минути

Златно момиче и актьор с приказна сватба в Милано
1757
преди 6 минути

Строги ограничения за водата в Кюстендил в жегите
2297
преди 22 минути

В сезона на пожарите: Ето какво съветват експертите за опазването на горите
1909
преди 37 минути

Ето какво каза Олег Невзоров след разпита
20864
преди 1 часа

13 загинали и 66 ранени при експлозия в газов комплекс в Катар
3617
преди 1 часа
НАЙ-ЧЕТЕНИ

Гърми нов скандал около Дара
556444
на 19.06.2026

ЛЮБОПИТНО! Вижте как посрещнаха Радев в парламента (ВИДЕО)
440894
на 16.06.2026

Култово! Киро се закани: Ще видите, като се случи (ВИДЕО/СНИМКИ)
433895
на 18.06.2026

ЕКШЪН В НС! Избърсаха пода на парламента с Цончо Ганев (ВИДЕО)
335130
на 18.06.2026

ПЪРВО В ПИК: ГЕРБ с извънреден конгрес заради Делян Добрев и Живко Тодоров
298456
преди 14 часа
























